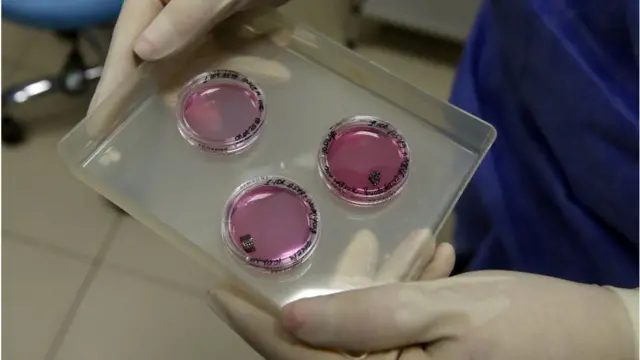
రక్త పరీక్ష

క్యాన్సర్: ఒక్క రక్త పరీక్షతో ‘50 రకాల క్యాన్సర్లను గుర్తించవచ్చు’

ఫొటో సోర్స్, Getty Images
- రచయిత, మైఖేల్ రాబర్ట్స్
- హోదా, హెల్త్ ఎడిటర్, బీబీసీ న్యూస్ ఆన్లైన్
ఒక సాధారణ రక్త పరీక్షతో 50 రకాలకు పైగా క్యాన్సర్లకు పరీక్ష చేయొచ్చునని.. ఎటువంటి లక్షణాలూ కనిపించకముందే గుర్తించవచ్చునని శాస్త్రవేత్తలు చెప్తున్నారు.
ఈ రక్త పరీక్ష ద్వారా క్యాన్సర్ ట్యూమర్లను మరింత ముందుగా గుర్తించవచ్చునని.. తద్వారా వాటికి చికిత్స చేయటం, నయం చేయటం సులభమవుతుందని నిపుణులు ఆశిస్తున్నారు.
ఈ పరీక్షలో క్యాన్సర్ ఉన్నట్లు గుర్తించిన ఫలితాల్లో 99 శాతం పైగా కచ్చితత్వం ఉందని ఈ రక్త పరీక్షను అభివృద్ధి చేసిన శాస్త్రవేత్తల బృందం తెలిపింది.
డాక్టర్లు ఈ పరీక్షలను రోగుల మీద ప్రయోగాత్మకంగా ఉపయోగిస్తున్నారని.. వీటిపై మరింత అధ్యయనం అవసరమని ఆనల్స్ ఆఫ్ ఆంకాలజీ వెల్లడించింది.
ప్రయోగాల ఫలితాలను బట్టి.. వ్యాధి ప్రారంభ దశల్లో కన్నా గానీ వ్యాధి ముదిరినప్పుడు మరింత మెరుగ్గా గుర్తిస్తున్నట్లు కనిపిస్తోంది. దీనివల్ల ఈ పరీక్షల ఉపయోగానికి పరిమితులు ఉండవచ్చు.
ఫొటో సోర్స్, Getty Images
ఎలా పని చేస్తుంది?
శరీర కణాల్లోని ట్యూమర్ల నుంచి రక్తప్రవాహంలోకి లీకయ్యే జన్యు సంకేతాల అవశేషాలు (కణాల నుంచి విడిపోయిన డీఎన్ఏ) వల్ల స్పష్టంగా కనిపించే రసాయనిక మార్పుల కోసం ఈ రక్త పరీక్షలో పరిశీలిస్తారు.
డానా-ఫార్బర్ క్యాన్సర్ ఇన్స్టిట్యూట్, హార్వర్డ్ మెడికల్ స్కూల్ పరిశోధకులు, బ్రిటన్లోని ఫ్రాన్సిస్ క్రిక్ ఇన్స్టిట్యూట్, యూనివర్సిటీ కాలేజ్ లండన్ శాస్త్రవేత్తలతో కలిసి ఈ కృషి చేపట్టారు. క్యాన్సర్ ఉన్న వారు, లేని వారు మొత్తం 4,000 మందికి పైగా వ్యక్తుల నమూనాలకు ప్రయోగాత్మకంగా ఈ పరీక్ష చేసి పరిశీలించారు.
పేగు క్యాన్సర్, ఊపిరితిత్తుల క్యాన్సర్, గర్భాశయ క్యాన్సర్ తదితర 50 పైగా క్యాన్సర్లు ఇందులో ఉన్నాయి.
అందులో 96 శాతం నమూనాల్లో అది ఏ రకం క్యాన్సరనేది ఈ పరీక్ష నిర్దుష్టంగా కనిపెట్టింది.

ఫొటో సోర్స్, Getty Images
నిపుణులు ఏమంటున్నారు?
ఈ రక్త పరీక్షను తయారు చేసిన గ్రెయిల్ అనే సంస్థ ఈ అధ్యయనానికి నిధులు సమకూర్చింది.
‘‘మొత్తం జనాభాకు ఏవైనా క్యాన్సర్లు ఉన్నాయేమో ప్రాథమిక తనిఖీ కోసం ఉపయోగపడే లక్షణాలు ఈ రక్త పరీక్షకు ఉన్నట్లు కనిపిస్తోంది’’ అని ఈ పరిశోధన బృంద సారథుల్లో ఒకరైన ప్రొఫెసర్ జెఫ్ ఆక్స్నార్డ్ పేర్కొన్నారు.
‘‘ఇటువంటి పరీక్ష ఎప్పుడు ఉపయోగంలోకి వస్తుందని అందరూ అడుగుతున్నారు. వేలాది మంది రోగుల మీద వైద్య పరంగా విజయవంతమైన ఫలితాలు ఇవ్వటంతో ఈ పరీక్షను పరిమితంగా వైద్య ప్రయోగాలకు అందించాం’’ అని ఆయన తెలిపారు.
ఈ రక్త పరీక్షను సాధారణ వాడుకలోకి తెచ్చే ముందు.. వాటి ఫలితాలను మరింత లోతుగా అర్థం చేసుకోవటానికి తాజా వైద్య ప్రయోగాల ఫలితాలను చూడాల్సి ఉంటుందన్నారు.
‘‘ఈ రంగం వేగంగా పురోగమిస్తోంది. రక్త పరీక్ష ద్వారా క్యాన్సర్ను నిర్ధరించటమనే ఆకాంక్ష నెరవేరుతుందనే ఆశలు కల్పిస్తోంది’’ అని ఆయన చెప్పారు.
ఇవి కూడా చదవండి.
- కరోనావైరస్: చైనాలో రెండు రాష్ట్రాల మధ్య చిక్కుకుపోయిన క్యాన్సర్ పేషెంట్... ఆ తర్వాత ఏమైంది?
- ‘క్యాన్సర్ చికిత్సతో గుండెపోటు వచ్చినా బతికి బయటపడ్డాను’
- అరుణ్ జైట్లీకి వచ్చిన సాఫ్ట్ టిష్యూ క్యాన్సర్ ఎలా వేధిస్తుంది...
- భారత్లో యువత క్యాన్సర్ బారిన ఎందుకు పడుతోంది
- ‘అన్ని రకాల క్యాన్సర్లకూ చికిత్స చేసే టెక్నిక్’
- క్యాన్సర్ను ఆర్టిఫిషియల్ ఇంటలిజెన్స్ (ఏఐ) డాక్టర్ల కన్నా కచ్చితంగా గుర్తిస్తుందా...
- కరోనావైరస్: 5జీ టెక్నాలజీతో కోవిడ్-19 వ్యాధి వ్యాపిస్తుందా?
- అమెరికాలో ఓ ఆడపులికి కరోనావైరస్
- కరోనావైరస్: ఇళ్లలో తయారుచేసే మాస్కులు ఎంత భద్రం?
(బీబీసీ తెలుగును ఫేస్బుక్, ఇన్స్టాగ్రామ్, ట్విటర్లో ఫాలో అవ్వండి. యూట్యూబ్లో సబ్స్క్రైబ్ చేయండి.)








